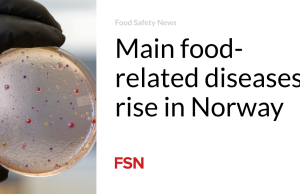
Penyakit utama yang berhubungan dengan makanan meningkat di Norwegia

Jika Anda menyukai muffin, Anda pasti akan disuguhi koleksi 21 resep menarik ini. Mulai dari rasa segar dan tajam dari Lemon Crumb Muffin dan Lemon Poppy Seed Muffin hingga kelezatan yang kaya seperti Double Chocolate Chip Muffin dan Apple Cheesecake Muffin, selalu ada sesuatu yang dapat memuaskan setiap keinginan. Baik Anda sedang ingin menikmati hidangan favorit musim gugur yang nyaman seperti Pumpkin Muffins atau buah klasik seperti Buttermilk Blueberry Muffins, camilan yang mudah dibuat ini sempurna untuk sarapan, camilan, atau kapan pun Anda menginginkan camilan manis dan memuaskan.
Muffin Streusel Tepung Jagung Berry yang Baik

Kredit Gambar: Jennifer Deremer/Tidak Sepenuhnya Rata-Rata
Muffin Streusel Tepung Jagung Berry yang Baik ini adalah kenikmatan pagi yang luar biasa, cocok untuk liburan di pantai atau piknik yang meriah! Bayangkan membenamkan gigi Anda ke dalam setiap muffin, di mana rasa renyah, manis, dan sedikit asin menari bersama dalam harmoni yang nikmat. Permata kecil ini adalah kesenangan sejati yang sayang untuk Anda lewatkan! Manjakan diri Anda dan ceriakan pagi Anda dengan muffin nikmat ini!
Dapatkan Resepnya: Muffin Streusel Tepung Jagung Berry yang Baik
Muffin Roti Pisang

Kredit Gambar: Erren Hart/Dapur ErrenUbah dapur Anda menjadi surga yang nyaman dengan aroma nikmat roti pisang yang baru dipanggang, dan temukan favorit keluarga baru! Muffin ini sangat lembab dan penuh rasa, menjadikannya teman yang sempurna untuk sarapan saat bepergian, piknik di bawah sinar matahari, atau bekal makan siang yang disukai semua orang.
Dapatkan Resepnya: Muffin Roti Pisang
Muffin Kue Remah

Kredit foto: Memanggang Momen
Manjakan diri dengan kue kopi krim asam kami yang lembut, diberi pita indah dengan kayu manis yang kaya dan dimahkotai dengan topping streusel yang lezat dan rapuh. Muffin kue remah ini adalah suguhan sempurna untuk memulai hari Anda dan menyegarkan pagi Anda!
Dapatkan Resepnya: Muffin Kue Remah
Muffin Roti Jagung Madu Stroberi

Kredit Gambar: Erren Hart/Dapur ErrenBayangkan stroberi berair yang dikemas dengan rasa, bersinar di bawah lapisan madu yang manis, semuanya terletak di dasar roti jagung yang lembab. Perpaduan tekstur dan rasa yang lezat ini merupakan suguhan yang sulit ditolak kapan pun sepanjang tahun!
Dapatkan Resepnya: Muffin Roti Jagung Madu Stroberi
Muffin Scone Blueberry

Kredit Gambar: Erren Hart/Dapur ErrenSiapa bilang Anda tidak bisa mendapatkan yang terbaik dari kedua dunia? Blueberry Scone Muffin ini memadukan tekstur lembut muffin dengan remah scone yang nikmat, semuanya penuh dengan blueberry yang berair. Ini adalah inovasi sarapan (atau camilan!) yang sayang untuk Anda lewatkan.
Dapatkan Resepnya: Muffin Scone Blueberry
Muffin Remah Pisang Kayu Manis

Kredit Gambar: Erren Hart/Dapur ErrenMuffin Remah Pisang Kayu Manis yang lezat ini adalah cara super mudah untuk memulai hari Anda. Mereka cepat disiapkan, dikemas dengan rasa, dan di atasnya diberi remah yang lezat, menjadikannya favorit sarapan baru Anda!
Dapatkan Resep: Muffin Remah Pisang Kayu Manis
Muffin Kayu Manis

Kredit Gambar: Marly McMillen/Yaitu Marly
Muffin yang menggugah selera ini memeluk Anda dengan hangatnya pelukan penuh kasih sayang dari nenek. Teksturnya yang lembut dan empuk serta aroma kayu manis yang sempurna di setiap gigitan menciptakan suguhan tak tertahankan yang membuat Anda ingin menikmati setiap remahnya. Anda akan merasa mustahil untuk menolak untuk kembali lagi selama beberapa detik—setelah Anda memanjakan diri, godaan lezatnya terlalu sayang untuk dilewatkan!
Dapatkan resepnya: Muffin Kayu Manis
Muffin Remah Lemon

Kredit foto: Memanggang Momen
Manjakan diri dengan muffin remah lemon yang lezat ini—cocok untuk sarapan atau camilan! Penuh dengan kelembapan dan kelembutan, setiap gigitan menawarkan rasa jeruk yang gurih, diakhiri dengan lapisan streusel yang kaya mentega. Anda tidak akan bisa menolak!
Dapatkan Resepnya: Muffin Remah Lemon
Muffin Pisang

Kredit foto: Memanggang Momen
Muffin pisang lembab dan empuk yang sangat mudah dibuat! Baik Anda menambahkan kenari, keping coklat, atau sekadar menikmatinya begitu saja, semuanya pasti menjadi favorit keluarga!
Dapatkan Resepnya: Muffin Pisang
Muffin Biji Poppy Lemon

Kredit foto: Memanggang Momen
Muffin Biji Poppy Lemon! Mereka sangat lembab dan dikemas dengan rasa jeruk yang cerah, ditambah kerenyahan yang enak dari biji poppy. Camilan pagi yang lezat!
Dapatkan Resepnya: Muffin Biji Poppy Lemon
Muffin Morning Glory

Kredit foto: Memanggang Momen
Muffin Morning Glory ini dikemas dengan makanan sehat seperti yogurt Yunani, wortel, dan apel. Rasanya cukup manis dan memiliki sentuhan kayu manis hangat yang enak.
Dapatkan Resepnya: Muffin Morning Glory
Muffin Blueberry Mentega

Kredit Gambar: Erren Hart/Dapur ErrenBayangkan muffin buttermilk yang lembut penuh dengan blueberry yang montok, semuanya diakhiri dengan topping remah kayu manis yang nikmat. Muffin ini tidak hanya “luar biasa” – tetapi juga ledakan visual dan rasa di setiap gigitan!
Dapatkan Resepnya: Muffin Blueberry Buttermilk
Muffin Remah Zucchini Persik

Kredit foto: Memanggang Momen
Nikmati cita rasa akhir musim panas dengan muffin remah zucchini persik yang menggugah selera ini! Dikemas dengan buah yang berair dan di atasnya diberi streusel berbumbu yang nikmat, muffin lembab ini adalah suguhan sempurna untuk merayakan musim ini. Jangan lewatkan kenikmatan musiman yang lezat ini!
Dapatkan Resepnya: Muffin Remah Zucchini Persik
Muffin Jumbo Gula Kayu Manis

Kredit Gambar: Erren Hart/Dapur ErrenBersiaplah untuk muffin raksasa ala toko roti yang penuh dengan kebaikan gula kayu manis dan di atasnya diberi streusel mentega yang lezat! Camilan lezat ini ternyata sangat mudah untuk dibuat dan pasti akan memuaskan keinginan Anda akan makanan manis!
Dapatkan Resepnya: Muffin Jumbo Gula Kayu Manis
Muffin Labu

Kredit foto: Memanggang Momen
Tidak ada yang mengalahkan muffin labu yang baru dipanggang untuk pagi musim gugur yang sibuk! Bentuknya tinggi, bengkak, dan lembab, dikemas dengan bumbu hangat.
Dapatkan Resepnya: Muffin Labu
Muffin Kue Keju Apel

Kredit Gambar: Erren Hart/Dapur ErrenSetiap gigitan merupakan perpaduan nikmat antara rasa pai apel yang menenangkan dan lapisan kue keju yang kaya, semuanya dibungkus dalam cangkang muffin yang empuk. Camilan ini sungguh luar biasa dan sempurna untuk memeriahkan acara apa pun!
Dapatkan Resepnya: Muffin Kue Keju Apel
Muffin Pistachio

Kredit Gambar: Erren Hart/Dapur ErrenMuffin Pistachio ini adalah mahakarya tekstur! Bayangkan remah lembut dan empuk bertabur pistachio cerah, semuanya diakhiri dengan bagian atas renyah yang menambah sentuhan kegembiraan di setiap gigitan.
Dapatkan Resepnya: Muffin Pistachio
Muffin Chocolate Chip Ganda

Muffin Chocolate Chip GandaManjakan selera Anda dengan resep Double Chocolate Chip Muffin yang menarik ini! Sempurna untuk sarapan atau camilan manis, muffin ini ringan, empuk, dan penuh dengan keping coklat yang kaya. Nikmati suguhan serbaguna ini kapan saja sepanjang hari dan puaskan hasrat tersebut dengan cara yang paling lezat!
Dapatkan Resepnya: Muffin Chocolate Chip Ganda
Muffin Raspberry

Kredit Gambar: Marly McMillen/Yaitu Marly
Raspberry yang asam dan berair mencuri perhatian dalam kelezatan warna rubi yang menakjubkan ini! Hanya satu gigitan dan Anda akan dibawa pergi ke kebun buah beri yang disinari matahari, merasakan semburan rasa asam manis yang menari-nari di langit-langit mulut Anda.
Dapatkan Resepnya: Muffin Raspberry
Muffin Jagung Buatan Sendiri yang Mudah

Kredit Gambar: Erren Hart/Dapur ErrenResep klasik ini hanyalah awal dari petualangan kuliner Anda! Biarkan kreativitas Anda bersinar saat Anda menyesuaikannya sesuai keinginan Anda dengan beberapa bahan sederhana. Taburkan sedikit madu untuk sentuhan manis yang nikmat, atau taburkan keju untuk rasa gurih yang akan membawa hidangan Anda ke tingkat yang lebih tinggi! Bersiaplah untuk meningkatkan permainan memasak Anda!
Dapatkan Resepnya: Muffin Jagung Buatan Sendiri yang Mudah
Muffin Keripik Coklat Labu

Kredit Gambar: Marly McMillen/Yaitu Marly
Muffin ini adalah perpaduan sempurna antara pai labu dan coklat, menawarkan kenikmatan yang kaya dan berbumbu di setiap gigitan. Penuh dengan keping coklat, rasanya sungguh tak tertahankan dan pasti akan memuaskan hasrat manis Anda!
Dapatkan resepnya: Muffin Keping Coklat Labu